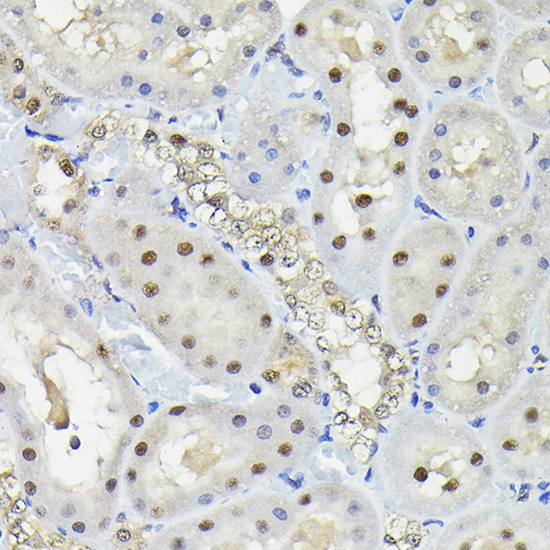

KPNA3 Rabbit Polyclonal Antibody
Other products for "KPNA3"
Specifications
| Product Data | |
| Applications | IHC, WB |
| Recommended Dilution | WB,1:500 - 1:2000 IHC,1:50 - 1:100 |
| Reactivities | Human, Mouse, Rat |
| Modifications | Unmodified |
| Host | Rabbit |
| Isotype | IgG |
| Clonality | Polyclonal |
| Immunogen | Recombinant fusion protein containing a sequence corresponding to amino acids 1-210 of human KPNA3 (NP_002258.2). |
| Formulation | Buffer: PBS with 0.02% sodium azide,50% glycerol,pH7.3. |
| Concentration | lot specific |
| Purification | Affinity purification |
| Conjugation | Unconjugated |
| Storage | Store at -20℃. Avoid freeze / thaw cycles. |
| Stability | Shelf life: one year from despatch. |
| Predicted Protein Size | 57kDa |
| Gene Name | karyopherin subunit alpha 3 |
| Database Link | |
| Background | The transport of molecules between the nucleus and the cytoplasm in eukaryotic cells is mediated by the nuclear pore complex (NPC), which consists of 60-100 proteins. Small molecules (up to 70 kD) can pass through the nuclear pore by nonselective diffusion while larger molecules are transported by an active process. The protein encoded by this gene belongs to the importin alpha family, and is involved in nuclear protein import. |
| Synonyms | hSRP1; importin-alpha-Q2; IPOA4; QIP2; SRP1; SRP1-gamma; SRP1gamma; SRP4 |
| Reference Data | |
Documents
| Product Manuals |
| FAQs |
| SDS |
{0} Product Review(s)
0 Product Review(s)
Submit review
Be the first one to submit a review
Product Citations
*Delivery time may vary from web posted schedule. Occasional delays may occur due to unforeseen
complexities in the preparation of your product. International customers may expect an additional 1-2 weeks
in shipping.






























































































































































































































































 Germany
Germany
 Japan
Japan
 United Kingdom
United Kingdom
 China
China